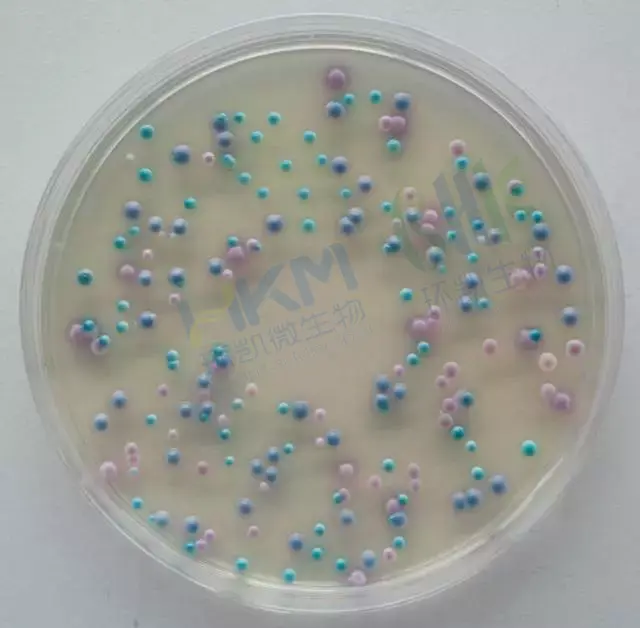

念珠菌显色培养基实验原理
发布时间:2019-10-30 浏览次数:5148
念珠菌显色培养基用途:
用于白色念珠菌分离和鉴定:念珠菌显色培养基根据酶底物法,通过显色来区别不同念珠菌,25-28℃培养48小时后,白色念球菌显蓝绿色,热带念珠菌显蓝灰色或铁蓝色,光滑念珠菌显紫色,克柔假丝酵母显粉色,其它念珠菌显白色,细菌被抑制。
注意:此培养基仅供实验室使用。
1)念珠菌显色培养基用法:
称取本品9.6g(可按4.8g/100ml的比例扩大或缩小),加入200ml蒸馏水或纯化水中,加热溶解并不停搅拌,煮沸不要超过1分钟。将加热后的培养基水浴冷却至45-50℃,轻轻地摇匀,倾入无菌平皿(9cm的15ml/皿,7cm的10ml/皿),琼脂完全凝固后,在36℃±1℃的培养箱中倒置放置0.5-1小时,备用。
2)注意:制备好的培养基一定要保持表面干燥,可在 37 ℃的培养箱中倒置放置 1-2 小时。
3)贮存:制备好的平板应立即使用,应避免光线直接照射。干粉培养基应放置于阴暗干燥处, 保存温度2-8℃,注意避光保存。
4)失效:干燥培养基超过保质期、结块和颜色变化都不能使用。
6)念珠菌显色培养基操作步骤
1、按国家标准、SN标准、FDA标准或其它方法制备样品液;
2、取样品液涂布或划线接种于平板上;
3、25-28℃培养48h。白色念珠菌典型特征为蓝绿色,热带念珠菌显蓝灰色或铁蓝色,光滑念珠菌显紫色,克柔假丝酵母显粉色,其它念珠菌显白色,细菌被抑制。
4 、对可疑白色念珠菌菌落可划线接种到PDA琼脂平板上,25-28℃培养24-48小时,挑取单菌落做镜检和生化试验。
7)质量控制:
1 、外观:此干燥培养基的粉末均匀,具有良好的流动性,呈乳白色。制备好的平板呈透明无色固体培养基。
2 、微生物试验:在25-30℃培养48小时:
此方法的局限性:本培养基鉴定白色念珠菌,少数情况下可能会出现假阳性或假阴性,需做其它补充试验。
8)念珠菌显色培养基典型特征:
念珠菌显色培养基典型特征为蓝绿色,热带念珠菌显蓝灰色或铁蓝色,光滑念珠菌显紫色,克柔假丝酵母显粉色,其它念珠菌显白色,细菌被抑制。






